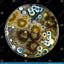
User's avatar

Why subscribe?
Subscribe to get full access to the newsletter and website. Never miss an update.
Stay up-to-date
You won’t have to worry about missing anything. Every new edition of the newsletter goes directly to your inbox.
Join the crew
Be part of a community of people who share your interests.
To find out more about the company that provides the tech for this newsletter, visit Substack.com.
Subscribe to KB’s From The Petri Dish
People
Let’s be clear, I am not a medical professional nor do I portray one in commercials. However, it is a family thing and multidisciplinary background in Marine Science. I do not have a big love of big Pharma nor for big CAM.
